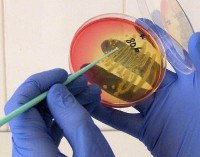

Другие названия и синонимы
Clamidiosis.
МКБ-10 коды
|
|
Описание
Хламидиоз - инфекционное заболевание, передающееся половым путём, вызываемое хламидиями (Chlamydia trachomatis).
Клиническая картина
Инкубационный период после заражения длится 10-14 дней. В основном болезнь передается половым путем, в том числе при орально-генитальных и анально-генитальных контактах. Использование презерватива надежно защищает от хламидий. Возможна передача инфекции от матери к ребенку при родах. Точно неизвестно, передается ли хламидиоз бытовым путем. Некоторые врачи придерживаются мнения, что подобный способ заражения может произойти в случае девочек, но практически невозможен у мальчиков и взрослых людей. Вне человеческого тела хламидия может просуществовать 1-2 дня, после чего погибает.
Одной из особенностей хламидийной инфекции является скрытое течение заболевания и долговременное внутриклеточное пребывание микроорганизмов без выраженных клинических проявлений.
При лёгких формах хламидиоза у мужчин могут появляться скудные слизисто-гнойные выделения из мочеиспускательного канала, ощущение дискомфорта в уретре, зуд, иногда болезненность при мочеиспускании, покраснение губок уретры. При осложнениях (воспалении яичек, их придатков, предстательной железы, поражении суставов, конъюнктивы глаз) возникает клиническая картина, соответствующая каждому из этих заболеваний.
У женщин проявления возникают ещё реже. Как правило, это выделения из цервикального канала, эрозии шейки матки, видимые только врачу на приёме, реже дискомфорт во влагалище, при мочеиспускании, зуд в тех же областях, а также в области заднего прохода. У обоих полов часто встречается поражение горла и миндалин, а также прямой кишки.
Наиболее грозными осложнениями хламидиоза являются бесплодие, выкидыши, внематочные беременности, аномалии развития плода.
После перенесенного заболевания, вызванного с. trachomatis, иммунитет нестойкий. Перенесенная инфекция не обеспечивает иммунитет к повторному заражению. Иммунный ответ поддерживается лишь при наличии возбудителя в организме.
Хламидийный проктит вполне вероятен и у женщин, однако наибольшему риску подвергаются именно мужчины, поскольку первопричина данной болезни прямой кишки - хламидиоз, который при поражении мочевыделительной системы сначала протекает преимущественно в форме уретрита, мужского заболевания. Хламидиями называются очень древние микроорганизмы, родственные бактериям. Они поражают мужчин, женщин и детей независимо от возраста. Пути передачи инфекции весьма разнообразны. Типичен для хламидиоза бытовой путь заражения, перенос микробов через использование общих предметов гигиены (полотенца, мочалки ). Ребенок может заразиться хламидиями во время родов, в половом тракте матери. Не исключено заражение плода еще до наступления родов. Главный путь передачи инфекции - половой. На сегодняшний день хламидиоз признан самым широко распространенным ЗППП в мире. В той или иной форме им болеют 3 млрд человек. Из пораженной уретры (у женщин обычно из влагалища) воспалительный процесс при хламидиозе распространяется в нескольких направлениях - на предстательную железу, следствием чего является хламидийный простатит, или на область верхних мочевых путей, вызывая хламидийный пиелонефрит. Третья мишень для микробов - прямая кишка, поражаемая чаще всего при попадании в нее через анус выделений из уретры. Что касается остальных заболеваний, то хламидийный простатит лечится в целом так же, как и прочие формы простатита. Хламидийный пиелонефрит в равной степени представлен и у мужчин, и у женщин, причем у женщин риск заболеть им гораздо выше. Переход воспалительного процесса с уретры на верхние мочевые пути (восходящая инфекция) как причина пиелонефритов несколько чаще отмечается у женщин. Установить факт заражения хламидийной инфекцией можно лишь путем лабораторного исследования, поскольку какими-либо специфическими симптомами хламидиоз не обладает. Можно догадываться о наличии активных хламидий, если проктиту предшествуют признаки уретрита - зуд и боли в уретре, а также частые позывы к мочеиспусканию. Однако это не обязательно указывает на хламидийный характер воспаления прямой кишки. Сходная картина нередко отмечается и при гонорейном проктите, называемом иногда гонореей прямой кишки. Последствия хламидиоза всегда тяжелые. Распространяясь из очага воспаления, микробы вызывают воспаления других органов, в первую очередь суставов, глаз и дыхательных путей. Это приводит к развитию полиартрита, конъюнктивита, фарингита, бронхита и даже пневмонии. Общими симптомами поражения прямой кишки являются зуд и жжение в заднем проходе, а также содержащие гной слизистые выделения из ануса. Слизь и гной выходят исключительно во время дефекации (если это происходит постоянно, то есть основания подозревать не проктит, а свищ прямой кишки или недостаточность анального сфинктера). Иногда отмечается появление в нижней части прямой кишки болезненных остроконечных бородавок - кондилом. Это свидетельствует о том, что к воспалительному процессу присоединилась папилломовирусная инфекция.
Хламидийный конъюнктивит - это поражение слизистой глаз хламидиями, выступает как сопутствующее заболевание хламидиоза.
-Инкубационный период у взрослых составляет от 2 до 7 дней до месяца. Часто протекает бессимптомно. Диагностируются как вялотекущие конъюнктивиты или блефариты с хроническим воспалением края век.
- В начале поражается один глаз, а в течении 2-6 дней у трети больных переходит и на второй, отмечается покраснение слизистой оболочки глаза, слезотечение, светобоязнь. У большинства больных с 3-5 дня определяется заболевание лимфатических узлов, расположенных перед ушной раковиной, евстахиит.
- Острая форма характеризуется выраженным отеком век, обильным слизисто-гнойным отделяемым, отеком конъюнктивы обоих век, поражением роговицы в виде мелких отечных и крупных гнойных участков уплотненной ткани с крупные фолликулами на нижнем веке, увеличение конъюнктивы верхнего века, уплотнение тканей конъюнктивы.
- При хронической стадии, наблюдается умеренный отек век и уплотнение ткани конъюнктивы, легкие слизистые выделения из глаз.
Ассоциированные симптомы: Болезненное мочеиспускание. Боль в голеностопе. Боль в мошонке. Боль в паху у мужчин. Боль в половом члене. Боль в промежности у мужчин. Боль в уретре. Боль в яичках. Боль внизу живота у мужчин. Выделения из влагалища (бели). Гиперчувствительность головки полового члена. Гнойные выделения из влагалища. Желтые выделения из влагалища. Жжение в заднем проходе. Зуд. Зуд полового члена. Истощение. Кровянистые выделения из влагалища. Разбитость. Рези при мочеиспускании у мужчин. Серые выделения из влагалища. Скудные месячные. Судороги. Судороги в ногах. Терминальное подтекание мочи. Увеличение паховых лимфоузлов. Учащенное мочеиспускание.
Одной из особенностей хламидийной инфекции является скрытое течение заболевания и долговременное внутриклеточное пребывание микроорганизмов без выраженных клинических проявлений.
При лёгких формах хламидиоза у мужчин могут появляться скудные слизисто-гнойные выделения из мочеиспускательного канала, ощущение дискомфорта в уретре, зуд, иногда болезненность при мочеиспускании, покраснение губок уретры. При осложнениях (воспалении яичек, их придатков, предстательной железы, поражении суставов, конъюнктивы глаз) возникает клиническая картина, соответствующая каждому из этих заболеваний.
У женщин проявления возникают ещё реже. Как правило, это выделения из цервикального канала, эрозии шейки матки, видимые только врачу на приёме, реже дискомфорт во влагалище, при мочеиспускании, зуд в тех же областях, а также в области заднего прохода. У обоих полов часто встречается поражение горла и миндалин, а также прямой кишки.
Наиболее грозными осложнениями хламидиоза являются бесплодие, выкидыши, внематочные беременности, аномалии развития плода.
После перенесенного заболевания, вызванного с. trachomatis, иммунитет нестойкий. Перенесенная инфекция не обеспечивает иммунитет к повторному заражению. Иммунный ответ поддерживается лишь при наличии возбудителя в организме.
Хламидийный проктит вполне вероятен и у женщин, однако наибольшему риску подвергаются именно мужчины, поскольку первопричина данной болезни прямой кишки - хламидиоз, который при поражении мочевыделительной системы сначала протекает преимущественно в форме уретрита, мужского заболевания. Хламидиями называются очень древние микроорганизмы, родственные бактериям. Они поражают мужчин, женщин и детей независимо от возраста. Пути передачи инфекции весьма разнообразны. Типичен для хламидиоза бытовой путь заражения, перенос микробов через использование общих предметов гигиены (полотенца, мочалки ). Ребенок может заразиться хламидиями во время родов, в половом тракте матери. Не исключено заражение плода еще до наступления родов. Главный путь передачи инфекции - половой. На сегодняшний день хламидиоз признан самым широко распространенным ЗППП в мире. В той или иной форме им болеют 3 млрд человек. Из пораженной уретры (у женщин обычно из влагалища) воспалительный процесс при хламидиозе распространяется в нескольких направлениях - на предстательную железу, следствием чего является хламидийный простатит, или на область верхних мочевых путей, вызывая хламидийный пиелонефрит. Третья мишень для микробов - прямая кишка, поражаемая чаще всего при попадании в нее через анус выделений из уретры. Что касается остальных заболеваний, то хламидийный простатит лечится в целом так же, как и прочие формы простатита. Хламидийный пиелонефрит в равной степени представлен и у мужчин, и у женщин, причем у женщин риск заболеть им гораздо выше. Переход воспалительного процесса с уретры на верхние мочевые пути (восходящая инфекция) как причина пиелонефритов несколько чаще отмечается у женщин. Установить факт заражения хламидийной инфекцией можно лишь путем лабораторного исследования, поскольку какими-либо специфическими симптомами хламидиоз не обладает. Можно догадываться о наличии активных хламидий, если проктиту предшествуют признаки уретрита - зуд и боли в уретре, а также частые позывы к мочеиспусканию. Однако это не обязательно указывает на хламидийный характер воспаления прямой кишки. Сходная картина нередко отмечается и при гонорейном проктите, называемом иногда гонореей прямой кишки. Последствия хламидиоза всегда тяжелые. Распространяясь из очага воспаления, микробы вызывают воспаления других органов, в первую очередь суставов, глаз и дыхательных путей. Это приводит к развитию полиартрита, конъюнктивита, фарингита, бронхита и даже пневмонии. Общими симптомами поражения прямой кишки являются зуд и жжение в заднем проходе, а также содержащие гной слизистые выделения из ануса. Слизь и гной выходят исключительно во время дефекации (если это происходит постоянно, то есть основания подозревать не проктит, а свищ прямой кишки или недостаточность анального сфинктера). Иногда отмечается появление в нижней части прямой кишки болезненных остроконечных бородавок - кондилом. Это свидетельствует о том, что к воспалительному процессу присоединилась папилломовирусная инфекция.
Хламидийный конъюнктивит - это поражение слизистой глаз хламидиями, выступает как сопутствующее заболевание хламидиоза.
-Инкубационный период у взрослых составляет от 2 до 7 дней до месяца. Часто протекает бессимптомно. Диагностируются как вялотекущие конъюнктивиты или блефариты с хроническим воспалением края век.
- В начале поражается один глаз, а в течении 2-6 дней у трети больных переходит и на второй, отмечается покраснение слизистой оболочки глаза, слезотечение, светобоязнь. У большинства больных с 3-5 дня определяется заболевание лимфатических узлов, расположенных перед ушной раковиной, евстахиит.
- Острая форма характеризуется выраженным отеком век, обильным слизисто-гнойным отделяемым, отеком конъюнктивы обоих век, поражением роговицы в виде мелких отечных и крупных гнойных участков уплотненной ткани с крупные фолликулами на нижнем веке, увеличение конъюнктивы верхнего века, уплотнение тканей конъюнктивы.
- При хронической стадии, наблюдается умеренный отек век и уплотнение ткани конъюнктивы, легкие слизистые выделения из глаз.
Ассоциированные симптомы: Болезненное мочеиспускание. Боль в голеностопе. Боль в мошонке. Боль в паху у мужчин. Боль в половом члене. Боль в промежности у мужчин. Боль в уретре. Боль в яичках. Боль внизу живота у мужчин. Выделения из влагалища (бели). Гиперчувствительность головки полового члена. Гнойные выделения из влагалища. Желтые выделения из влагалища. Жжение в заднем проходе. Зуд. Зуд полового члена. Истощение. Кровянистые выделения из влагалища. Разбитость. Рези при мочеиспускании у мужчин. Серые выделения из влагалища. Скудные месячные. Судороги. Судороги в ногах. Терминальное подтекание мочи. Увеличение паховых лимфоузлов. Учащенное мочеиспускание.
|
|
Причины
Хламидии - мелкие неподвижные внутриклеточные микроорганизмы. Они не способны самостоятельно синтезировать энергию и поэтому паразитируют в клетках цилиндрического эпителия, выстилающих мочеиспускательный канал, протоки предстательной железы, придатка яичка, семявыносящие пути, влагалище, шейку матки, зону анального канала, ротовую полость, ткани яичников и маточных труб. В отдельных случаях хламидии способны вызывать распространённый процесс, поражая конъюнктивы глаз, суставы, другие органы. Такой процесс называется болезнью Рейтера.
Лечение
Применяются антибиотиками тетрациклинового ряда, макролиды и фторхинолоны, глазные капли местно, антигистаминные препараты. Лечение продолжается не менее 21 дня. По окончании лечения необходимо контрольное обследование (не менее 2-х отрицательных результатов) во избежании суперинфекции.
Лечение хламидийного проктита заключается в подавлении воспалительного процесса и борьбе с инфекцией. Воспалительные явления устраняются путем применения свечей с протарголом, который обладает также вяжущим и антисептическим действием. Боли купируются с помощью микроклизм с экстрактом белладонны (не более 0,02 г экстракта на одну клизму) либо свеч с алкалоидами белладонны. Прочие лечебные процедуры проводит уролог. Врач же удаляет и кондиломы, если они появились.
Лечение хламидийного проктита заключается в подавлении воспалительного процесса и борьбе с инфекцией. Воспалительные явления устраняются путем применения свечей с протарголом, который обладает также вяжущим и антисептическим действием. Боли купируются с помощью микроклизм с экстрактом белладонны (не более 0,02 г экстракта на одну клизму) либо свеч с алкалоидами белладонны. Прочие лечебные процедуры проводит уролог. Врач же удаляет и кондиломы, если они появились.